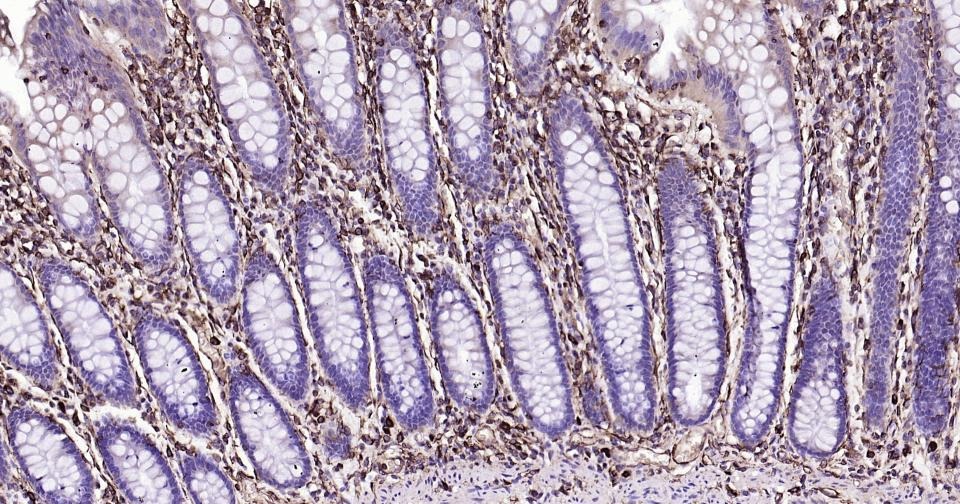

购物车
 您的购物车当前为空
您的购物车当前为空
Anti-Vimentin Polyclonal Antibody 是一种 Rabbit 抗体,靶向 Vimentin。Anti-Vimentin Polyclonal Antibody 可用于 FCM, ICC/IF, IF, IHC-Fr, IHC-P, WB。
别名 vimentin, HEL113, CTRCT30
Anti-Vimentin Polyclonal Antibody 是一种 Rabbit 抗体,靶向 Vimentin。Anti-Vimentin Polyclonal Antibody 可用于 FCM, ICC/IF, IF, IHC-Fr, IHC-P, WB。
| 规格 | 价格 | 库存 | 数量 |
|---|---|---|---|
| 50 μL | ¥ 1,160 | 5日内发货 | |
| 100 μL | ¥ 1,970 | 5日内发货 | |
| 200 μL | ¥ 2,785 | 5日内发货 |
TargetMol的所有产品仅用作科学研究或药证申报,不能被用于人体,我们不向个人提供产品和服务。请您遵守承诺用途,不得违反法律法规规定用于任何其他用途。
| 产品描述 | Anti-Vimentin Polyclonal Antibody is a Rabbit antibody targeting Vimentin. Anti-Vimentin Polyclonal Antibody can be used in FCM, ICC/IF, IF, IHC-Fr, IHC-P, WB. |
| 别名 | vimentin, HEL113, CTRCT30 |
| Ig Type | IgG |
| 反应种属 | Human,Mouse,Rat (predicted:Chicken,Pig,Cow,Goat) |
| 验证活性 | 1. Blank control: Jurkat cells (blue). Primary Antibody: Rabbit Anti-Vimentin antibody antibody (TMAB-01964), Dilution: 1 μg in 100 μL 1X PBS containing 0.5% BSA; Isotype Control Antibody: Rabbit Igg (orange),used under the same conditions); Secondary Antibody: Goat anti-rabbit IgG-Pe (white blue), Dilution: 1:200 in 1 X PBS containing 0.5% BSA. Protocol The cells were fixed with 2% paraformaldehyde (10 min), then permeabilized with 90% ice-cold methanol for 30 min on ice. Primary antibody (TMAB-01964, 1 μg/1x10^6 cells) were incubated for 30 min on the ice, followed by 1 X PBS containing 0.5% BSA + 10% goat serum (15 min) to block non-specific protein-protein interactions. Then the Goat Anti-rabbit IgG/PE antibody was added into the blocking buffer mentioned above to react with the primary antibody at 1/200 dilution for 30 min on ice. 2. Tissue/cell: U-2OS cell; 4% Paraformaldehyde-fixed; Triton X-100 at room temperature for 20 min; Blocking buffer (normal goat serum) at 37°C for 20 min; Antibody incubation with (Vimentin) Polyclonal Antibody, Unconjugated (TMAB-01964) 1:50, 90 minutes at 37°C; followed by a conjugated Goat Anti-Rabbit IgG antibody at 37°C for 90 minutes, DAPI (5 μg/ml, blue) was used to stain the cell nucleus. 3. Blank control: A549. Primary Antibody (green line): Rabbit Anti-Vimentin antibody (TMAB-01964) Dilution: 1 μg/10^6 cells; Isotype Control Antibody (orange line): Rabbit IgG. Secondary Antibody: Goat anti-rabbit IgG-AF488 Dilution: 1 μg/test. Protocol The cells were fixed with 4% PFA (10 min at room temperature) and then permeabilized with 90% ice-cold methanol for 20 min at-20°C. The cells were then incubated in 5% BSA to block non-specific protein-protein interactions for 30 min at room temperature. Cells stained with Primary Antibody for 30 min at room temperature. The secondary antibody used for 40 min at room temperature. 4. Tissue/cell: U251 cell; 4% Paraformaldehyde-fixed; Triton X-100 at room temperature for 20 min; Blocking buffer (normal goat serum) at 37°C for 20 min; Antibody incubation with (Vimentin) Polyclonal Antibody, Unconjugated (TMAB-01964) 1:50, 90 minutes at 37°C; followed by a conjugated Goat Anti-Rabbit IgG antibody at 37°C for 90 minutes, DAPI (blue) was used to stain the cell nucleus. 5. Tissue/cell: HeLa cell; 4% Paraformaldehyde-fixed; Triton X-100 at room temperature for 20 min; Blocking buffer (normal goat serum) at 37°C for 20 min; Antibody incubation with (Vimentin) Polyclonal Antibody, Unconjugated (TMAB-01964) 1:50, 90 minutes at 37°C; followed by a conjugated Goat Anti-Rabbit IgG antibody at 37°C for 90 minutes, DAPI (blue) was used to stain the cell nucleus. 6. Tissue/cell: U-87MG cell; 4% Paraformaldehyde-fixed; Triton X-100 at room temperature for 20 min; Blocking buffer (normal goat serum) at 37°C for 20 min; Antibody incubation with (Vimentin) Polyclonal Antibody, Unconjugated (TMAB-01964) 1:100, 90 minutes at 37°C; followed by a conjugated Goat Anti-Rabbit IgG antibody at 37°C for 90 minutes, DAPI (blue) was used to stain the cell nucleus. 7. Sample: Hela (Human) Cell Lysate at 30 μg Hela KO Vimentin (Human) Cell Lysate at 30 μg Primary: Anti-Vimentin (TMAB-01964) at 1/1000 dilution Secondary: IRDye800CW Goat Anti-Rabbit IgG at 1/20000 dilution Predicted band size: 53 kDa Observed band size: 53 kDa 8. Paraformaldehyde-fixed, paraffin embedded Mouse Colon; Antigen retrieval by boiling in sodium citrate buffer (pH6.0) for 15 min; Antibody incubation with Vimentin Polyclonal Antibody, Unconjugated (TMAB-01964) at 1:200 overnight at 4°C, followed by conjugation to the SP Kit (Rabbit) and DAB staining. 9. Paraformaldehyde-fixed, paraffin embedded Rat Colon; Antigen retrieval by boiling in sodium citrate buffer (pH6.0) for 15 min; Antibody incubation with Vimentin Polyclonal Antibody, Unconjugated (TMAB-01964) at 1:200 overnight at 4°C, followed by conjugation to the SP Kit (Rabbit) and DAB staining. 10. Paraformaldehyde-fixed, paraffin embedded Human Colon; Antigen retrieval by boiling in sodium citrate buffer (pH6.0) for 15 min; Antibody incubation with Vimentin Polyclonal Antibody, Unconjugated (TMAB-01964) at 1:200 overnight at 4°C, followed by conjugation to the SP Kit (Rabbit) and DAB staining. 11. Paraformaldehyde-fixed, paraffin embedded Mouse Kidney; Antigen retrieval by boiling in sodium citrate buffer (pH6.0) for 15 min; Antibody incubation with Vimentin Polyclonal Antibody, Unconjugated (TMAB-01964) at 1:200 overnight at 4°C, followed by conjugation to the SP Kit (Rabbit) and DAB staining. 12. Paraformaldehyde-fixed, paraffin embedded Rat Kidney; Antigen retrieval by boiling in sodium citrate buffer (pH6.0) for 15 min; Antibody incubation with Vimentin Polyclonal Antibody, Unconjugated (TMAB-01964) at 1:200 overnight at 4°C, followed by conjugation to the SP Kit (Rabbit) and DAB staining. 13. Paraformaldehyde-fixed, paraffin embedded Human Kidney; Antigen retrieval by boiling in sodium citrate buffer (pH6.0) for 15 min; Antibody incubation with Vimentin Polyclonal Antibody, Unconjugated (TMAB-01964) at 1:200 overnight at 4°C, followed by conjugation to the SP Kit (Rabbit) and DAB staining. 14. Paraformaldehyde-fixed, paraffin embedded Human Cervical Cancer; Antigen retrieval by boiling in sodium citrate buffer (pH6.0) for 15 min; Antibody incubation with Vimentin Polyclonal Antibody, Unconjugated (TMAB-01964) at 1:200 overnight at 4°C, followed by conjugation to the SP Kit (Rabbit) and DAB staining. 15. Paraformaldehyde-fixed, paraffin embedded Human Tonsil; Antigen retrieval by boiling in sodium citrate buffer (pH6.0) for 15 min; Antibody incubation with Vimentin Polyclonal Antibody, Unconjugated (TMAB-01964) at 1:200 overnight at 4°C, followed by conjugation to the SP Kit (Rabbit) and DAB staining. 16. Paraformaldehyde-fixed, paraffin embedded Human Small Intestine; Antigen retrieval by boiling in sodium citrate buffer (pH6.0) for 15 min; Antibody incubation with Vimentin Polyclonal Antibody, Unconjugated (TMAB-01964) at 1:200 overnight at 4°C, followed by conjugation to the SP Kit (Rabbit) and DAB staining. 17. Paraformaldehyde-fixed, paraffin embedded Human Uterus; Antigen retrieval by boiling in sodium citrate buffer (pH6.0) for 15 min; Antibody incubation with Vimentin Polyclonal Antibody, Unconjugated (TMAB-01964) at 1:200 overnight at 4°C, followed by conjugation to the SP Kit (Rabbit) and DAB staining. 18. Paraformaldehyde-fixed, paraffin embedded Human Breast Cancer; Antigen retrieval by boiling in sodium citrate buffer (pH6.0) for 15 min; Antibody incubation with Vimentin Polyclonal Antibody, Unconjugated (TMAB-01964) at 1:200 overnight at 4°C, followed by conjugation to the SP Kit (Rabbit) and DAB staining. 19. Paraformaldehyde-fixed, paraffin embedded Human Endometrium Cancer; Antigen retrieval by boiling in sodium citrate buffer (pH6.0) for 15 min; Antibody incubation with Vimentin Polyclonal Antibody, Unconjugated (TMAB-01964) at 1:200 overnight at 4°C, followed by conjugation to the SP Kit (Rabbit) and DAB staining. 20. 25 μg total protein per Lane of various lysates probed with Vimentin polyclonal antibody, unconjugated (TMAB-01964) at 1:1000 dilution and 4°C overnight incubation. Followed by conjugated secondary antibody incubation at RT for 60 min. 21. Paraformaldehyde-fixed, paraffin embedded Rat Colon; Antigen retrieval by boiling in sodium citrate buffer (pH6.0) for 15 min; Antibody incubation with Vimentin Polyclonal Antibody, Unconjugated (TMAB-01964) at 1:200 overnight at 4°C. Followed by conjugated Goat Anti-Rabbit IgG antibody (green), DAPI (blue) was used to stain the cell nucleus. 22. Paraformaldehyde-fixed, paraffin embedded Mouse Colon; Antigen retrieval by boiling in sodium citrate buffer (pH6.0) for 15 min; Antibody incubation with Vimentin Polyclonal Antibody, Unconjugated (TMAB-01964) at 1:200 overnight at 4°C. Followed by conjugated Goat Anti-Rabbit IgG antibody (green), DAPI (blue) was used to stain the cell nucleus. 23. Paraformaldehyde-fixed, paraffin embedded Human Colon Cancer; Antigen retrieval by boiling in sodium citrate buffer (pH6.0) for 15 min; Antibody incubation with Vimentin Polyclonal Antibody, Unconjugated (TMAB-01964) at 1:200 overnight at 4°C. Followed by conjugated Goat Anti-Rabbit IgG antibody (green), DAPI (blue) was used to stain the cell nucleus. |
| 应用 | FCMICC/IFIFIHC-FrIHC-PWB |
| 推荐剂量 | FCM=1 μg/Test; ICC/IF=1:100-500; IF=1:200-1000; IHC-Fr=1:200-1000; IHC-P=1:200-1000; WB=1:1000-5000 |
| 抗体种类 | Polyclonal |
| 宿主来源 | Rabbit |
| 亚细胞定位 | Cytoplasm. |
| 组织特异性 | Highly expressed in fibroblasts, somev expression in T- and B-lymphocytes, and little or no expression in Burkitt's lymphoma cell lines. Expressed in many hormone-independent mammary carcinoma cell lines. |
| 构建方式 | Polyclonal Antibody |
| 纯化方式 | Protein A purified |
| 性状 | Liquid |
| 缓冲液 | 0.01M TBS (pH7.4) with 1% BSA, 0.02% Proclin300 and 50% Glycerol. |
| 浓度 | 1 mg/mL |
| 研究背景 | This gene encodes a member of the intermediate filament family. Intermediate filamentents, along with microtubules and actin microfilaments, make up the cytoskeleton. The protein encoded by this gene is responsible for maintaining cell shape, integrity of the cytoplasm, and stabilizing cytoskeletal interactions. It is also involved in the immune response, and controls the transport of low-density lipoprotein (LDL)-derived cholesterol from a lysosome to the site of esterification. It functions as an organizer of a number of critical proteins involved in attachment, migration, and cell signaling. Mutations in this gene causes a dominant, pulverulent cataract.[provided by RefSeq, Jun 2009] |
| 免疫原 | KLH conjugated synthetic peptide: human Vimentin |
| 抗原种属 | Human |
| 基因名称 | VIM |
| 基因ID | |
| 蛋白名称 | Vimentin |
| Uniprot ID | |
| 研究领域 | Intracellular,Endoderm,Vimentin,vimentin,Neuroregeneration,Neurogenesis,Neural Stem Cell marker,Ectoderm,Tumor biomarkers |
| 功能 | Vimentins are class-III intermediate filaments found in various non-epithelial cells, especially mesenchymal cells. Vimentin is attached to the nucleus, endoplasmic reticulum, and mitochondria, either laterally or terminally.Involved with LARP6 in the stabilization of type I collagen mRNAs for CO1A1 and CO1A2. |
| 分子量 | Theoretical: 53 kDa. Actual: 53 kDa. |
| 储存方式 | Store at -20°C or -80°C for 12 months. Avoid repeated freeze-thaw cycles. |
| 运输方式 | Shipping with blue ice. |